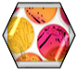

Eurolab S.r.l.
Viale Mare Jonio , 4
89041 MARINA DI CAULONIA (RC)
P.IVA: 02052720808
Eurolab S.r.l. - copyright 2017 © riservati
PRIVACY POLICY
Cookie policy
Home
Ormai da oltre quindici anni la Società Eurolab srl si è contraddistinta sul territorio per l’attività analitica e consulenziale, si colloca nei settori agro-alimentare, e ambientale. Con un laboratorio di 200 mq, uno staff tecnico costantemente aggiornato ed attrezzature analitiche d’alto livello, il Laboratorio Eurolab srl risponde con professionalità alle esigenze della clientela, sia per ciò che riguarda l’efficace esecuzione d’analisi di vario tipo che in merito alla valutazione tecnica ed alla consulenza specifica su aspetti più complessi che spesso accompagnano le normali determinazioni analitiche. Al fine di garantire la massima affidabilità nel prelievo dei campioni, nell’effettuazione delle analisi e nella validazione dei risultati, il Laboratorio Eurolab srl ha sviluppato il Sistema di Qualità secondo le linee della norma UNI CEI EN ISO/IEC 17025:2018, ed ha ricevuto l’accreditamento ACCREDIA per le prove prove oggetto dell'ACCREDITAMENTO (elenco prove) il quale operando secondo la norma ISO/IEC 17011, verifica e sorveglia nel tempo la conformità dei Laboratori rispetto alla norma UNI CEI EN ISO/IEC 17025:2018 ed alle prescrizioni ACCREDIA, Ente che accredita i Laboratori per qualsiasi tipo di prova sui cui risultati i consulenti possono basare il proprio lavoro.

Eurolab S.r.l.
Viale Mare Jonio , 4
89041 MARINA DI CAULONIA (RC)
P.IVA: 02052720808
Eurolab S.r.l. - copyright 2017 © riservati
PRIVACY POLICY
Cookie policy